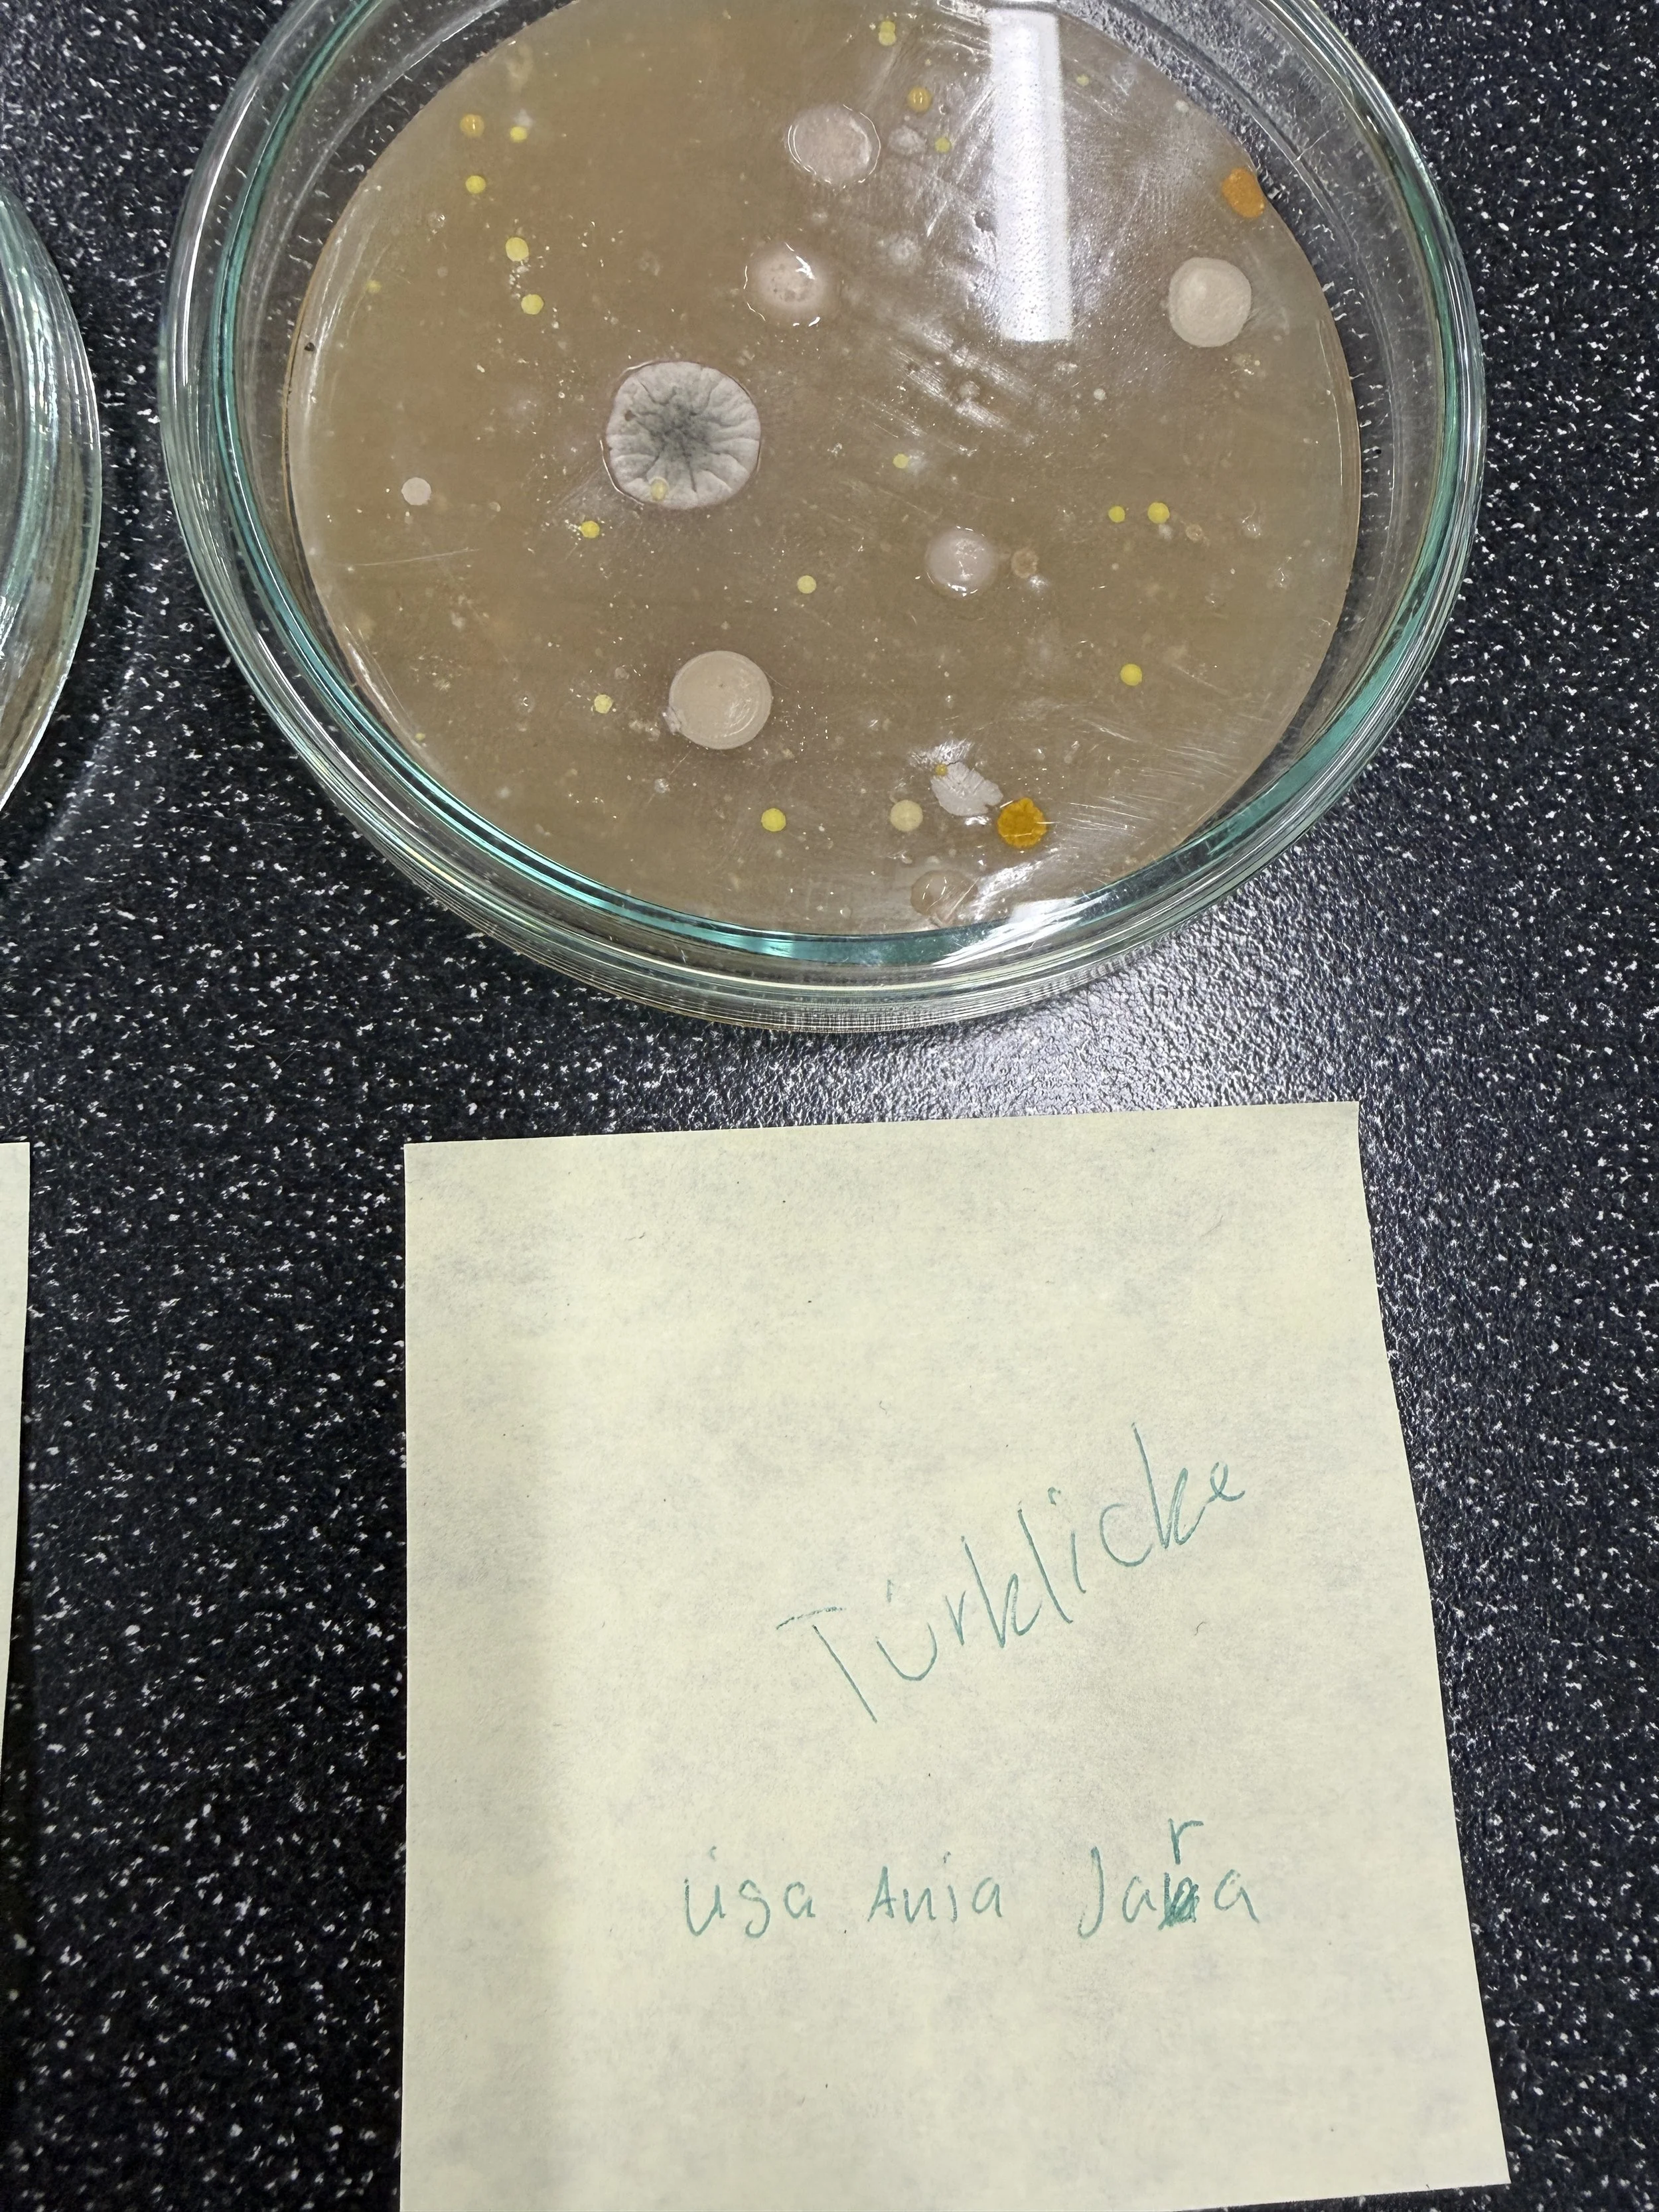
IMG_1988.JPG
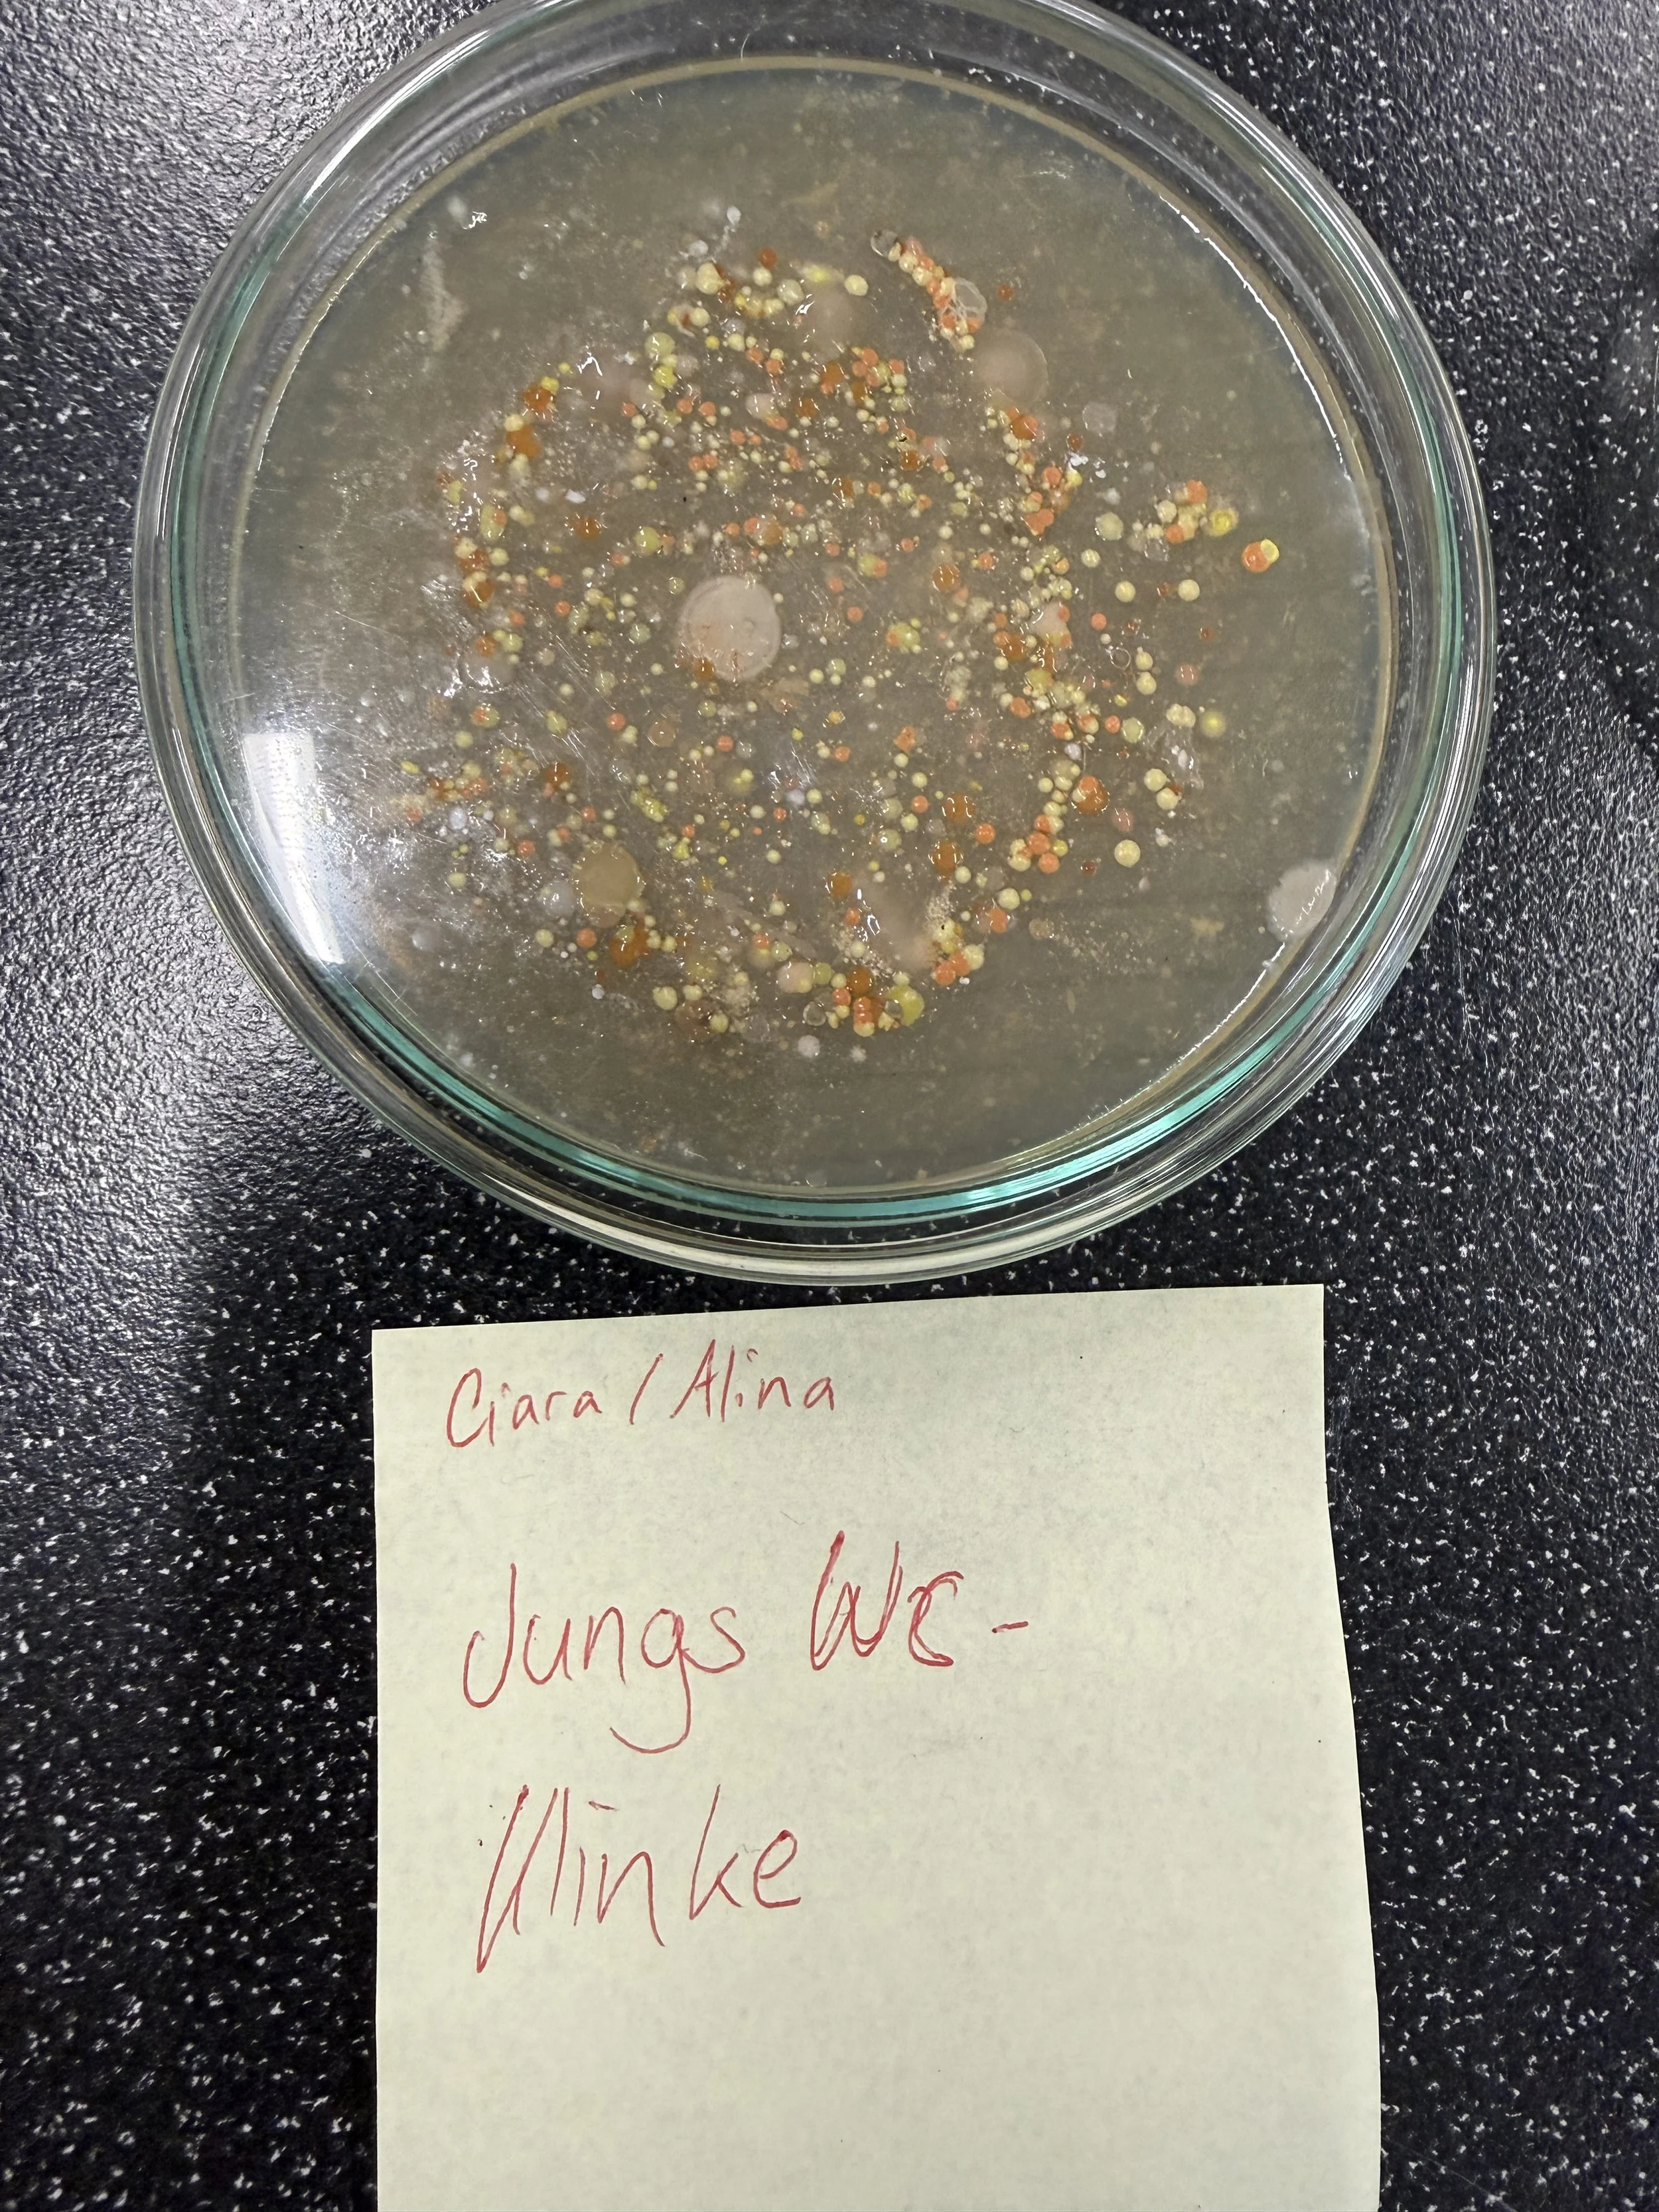
IMG_1989.JPG
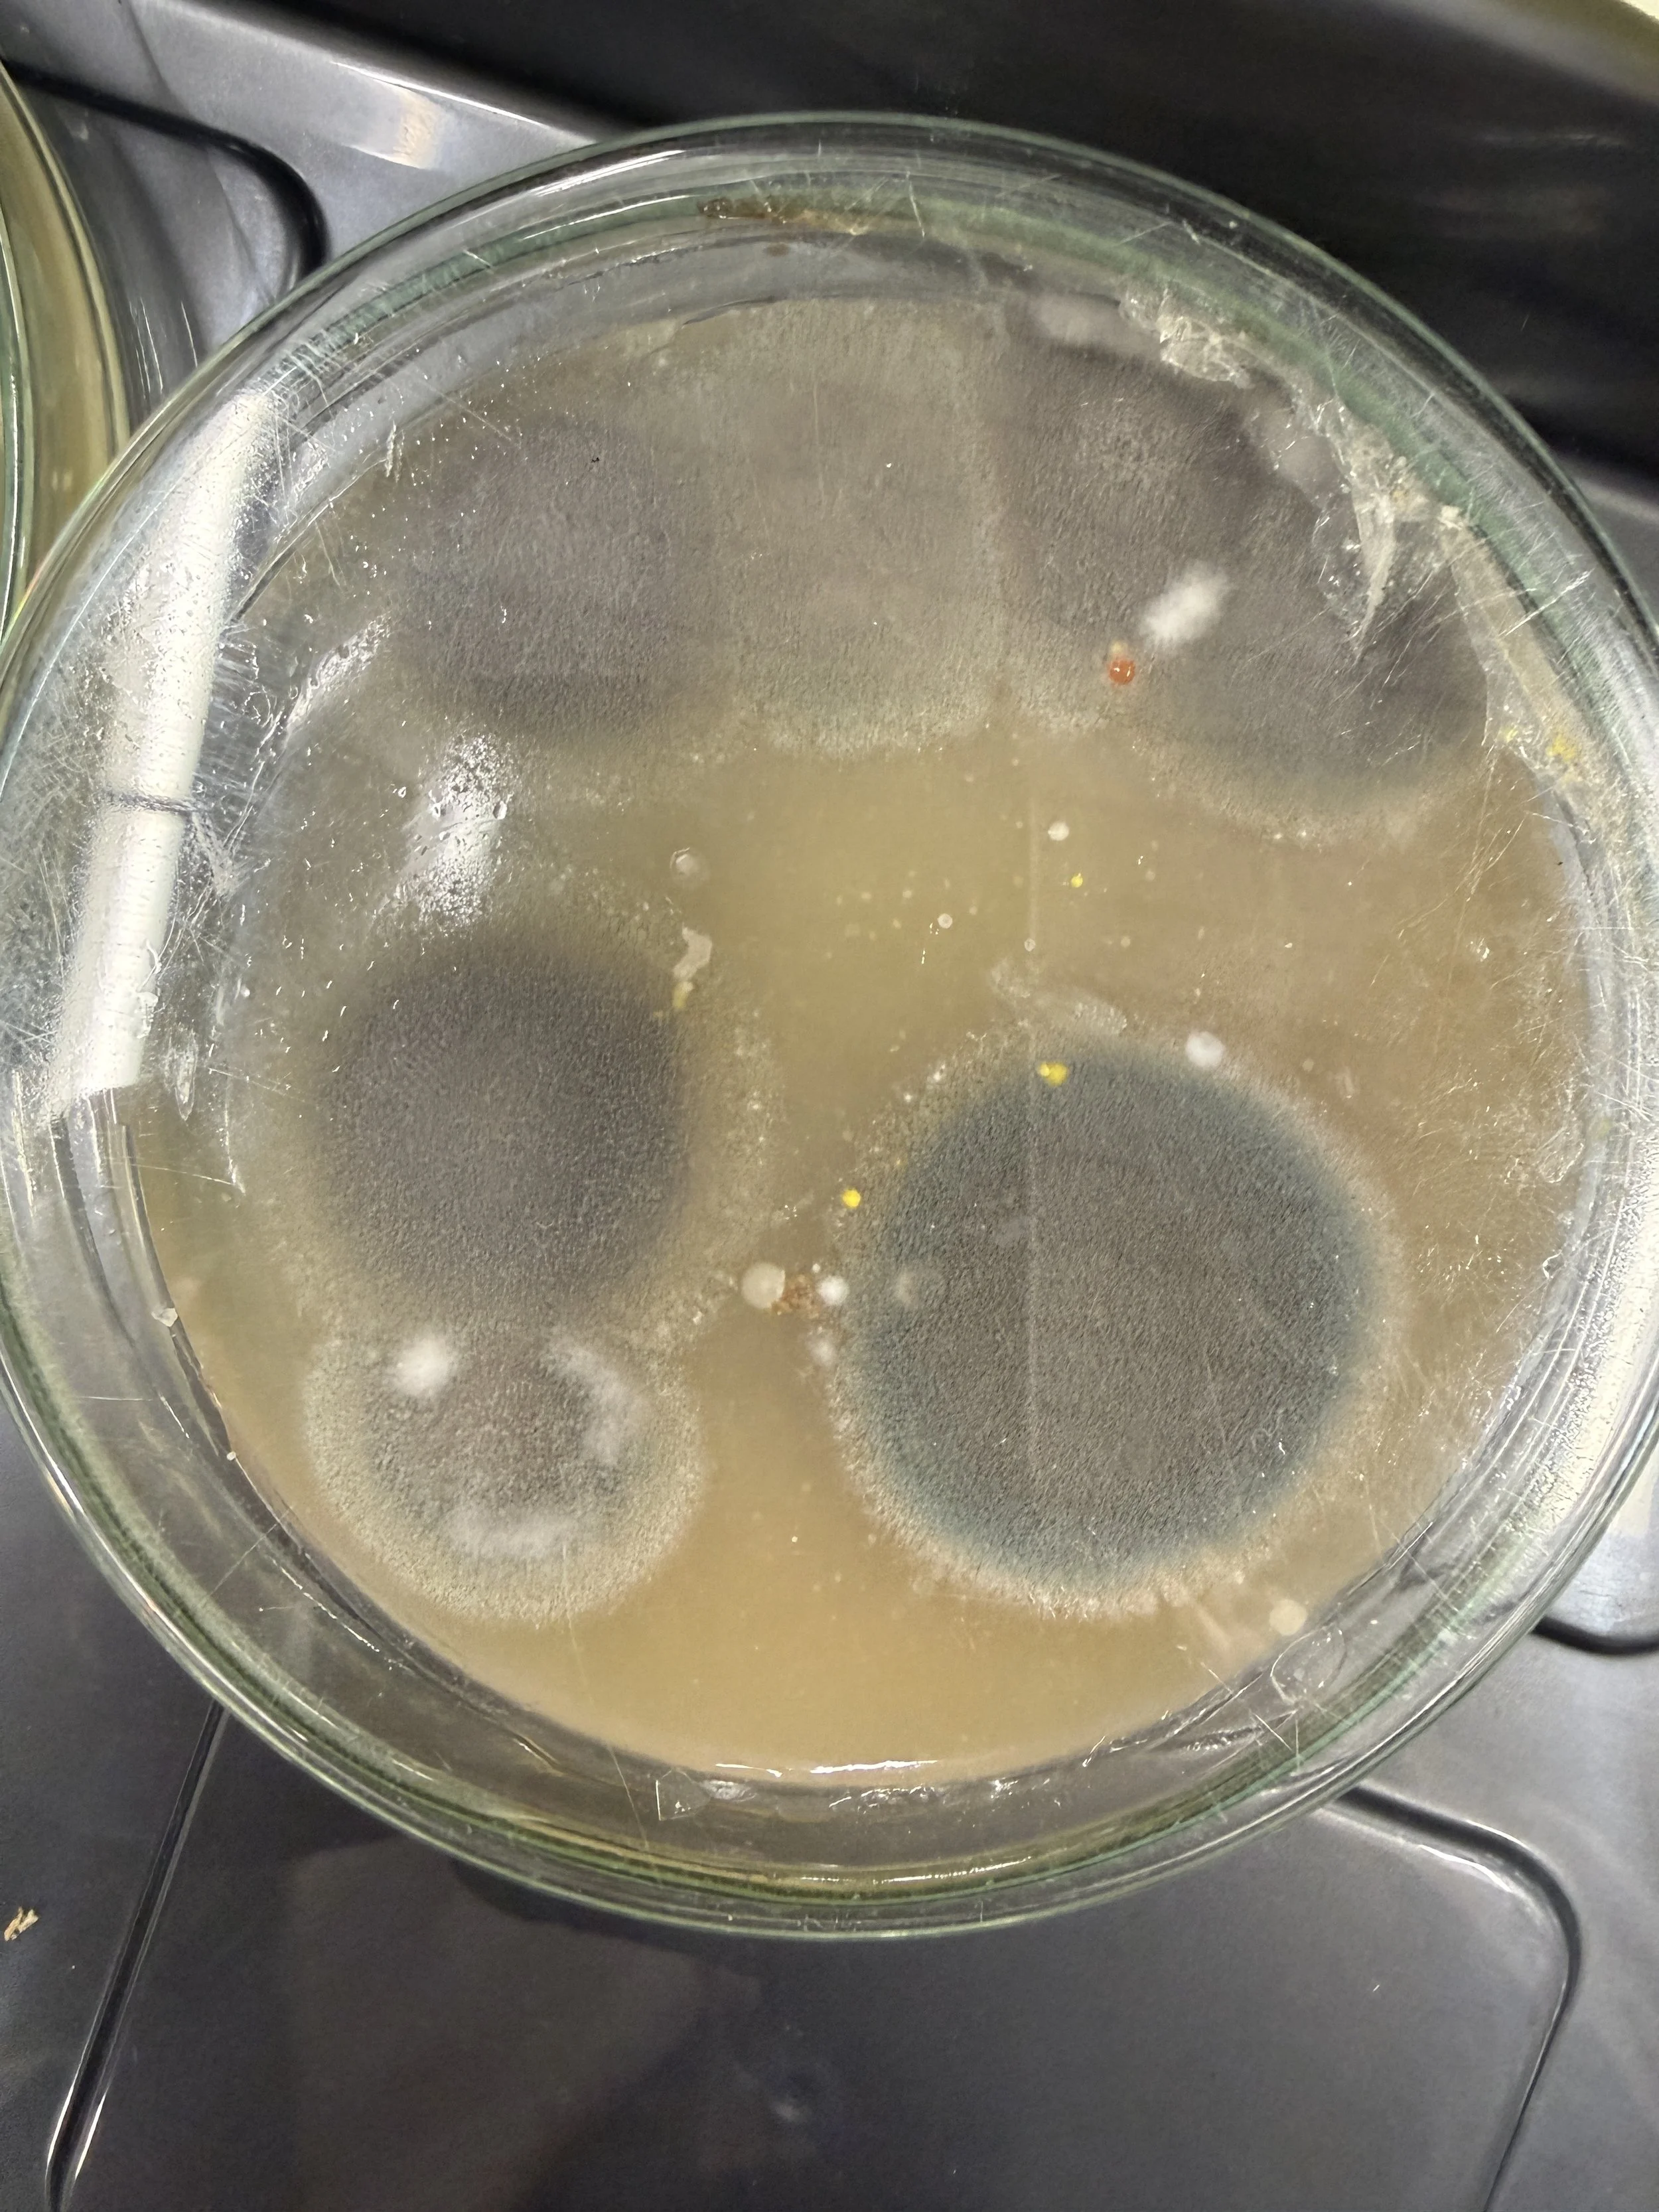
IMG_1991.JPG

(NT) Experiment 1: Keime auf der Türe sichtbar machen
Unsichtbares wird sichtbar. Mit diesem einfachen Natur & Technik Experiment stellst du deine eigene Agar-Nährlösung her und gehst auf Spurensuche im Alltag. Im Klassenzimmer lernen wir für die Schule – doch dieses Experiment zeigt, was wirklich um uns herum lebt.
👉 Abstriche von Türgriffen, Smartphones, Böden oder sogar dem WC
👉 Wachstum von Mikroorganismen in der Petrischale beobachten
👉 Ergebnisse vergleichen, hinterfragen und verstehen
Warum ist dieses Experiment so wertvoll?
• Es macht Mikroorganismen sichtbar, die sonst verborgen bleiben
• Es fördert Neugier und Forschergeist
• Es zeigt, wie wichtig Hygiene und Umweltfaktoren sind
• Es verbindet Theorie mit echtem Leben – genau das, was moderner Unterricht braucht Schülerinnen und Schüler erleben hier, dass Lernen nicht nur im Buch passiert, sondern direkt vor ihrer Nase.
Was zeigt das Experiment konkret?
🧫 Überall leben Mikroorganismen – auch dort, wo wir es nicht erwarten
🧫 Unterschiedliche Oberflächen haben unterschiedliche Keimbelastung
🧫 Bedingungen wie Wärme beeinflussen Wachstum massiv
🧫 Wissenschaft beginnt mit Beobachtung, Neugier und Fragen
Ein Experiment, das Grenzen sprengt – vom Klassenzimmer in den Alltag. Die Anleitung findest du hier unten:
Um was geht es?
Bakterien, Schimmel- und Hefepilze gibt es überall in der Natur.
Wir leben mittendrin. Dabei gibt es harmlose und gesundheitsschädliche Arten. z.B. macht der Edelschimmel «Penicillium roqueforti» den französischen Roquefort Käse würzig und köstlich. Auf der anderen Seite produziert der Grauschimmel, wie wir ihn auf altem Brot, Konfitüre, Früchten oder feuchten Wänden finden, Mykotoxine, eine für den Menschen giftige Substanz.
Der menschliche Körper ist besiedelt von Bakterien. Auf der Haut oder im Darm übernehmen sie wichtige Funktionen für unsere Gesundheit. Ein erwachsener Mensch ist von über 2 kg Bakterien besiedelt, dabei die meisten im Darm. Es gibt aber auch hier unerwünschte Typen wie das «Escherichia coli» Bakterium, das Darmblutungen auslösen kann.
In der Lebensmittel-, Pharma- und Medizinaltechnik- industrie sowie in Spitälern und Operationssälen sind Bakterien und Schimmelpilze unerwünscht. Sie gefährden unsere Gesundheit durch verdorbene Lebensmittel oder bakterielle Infektionen bei Operationen. Die Hygienevorschriften sind in diesen Bereichen besonders streng. Die Raumluft wird über Filter gereinigt, Material darf nur über Schleusen in die Bereiche eingebracht werden und die Menschen müssen sich einem definierten Reinigungsverfahren unterziehen. In diesen geschützten Räumen wird auch regelmässig die Hygiene überwacht und geprüft. An verschiedenen Stellen der Infrastruktur, Produkten und an Menschen werden Proben genommen und diese auf einem Nährboden gezüchtet. So kann bestimmt werden, welche spezifischen Keime (Krankheitserreger) in welcher Menge gefunden wurden. Dieses Verfahren nennt man mikrobiologische Untersuchung. Durch Abklatschen von Oberflächen mit entsprechenden Nährböden werden die Proben gesammelt. Ganz ähnlich machen wir das jetzt auch…
Auftrag für die Schülerinnen und Schüler